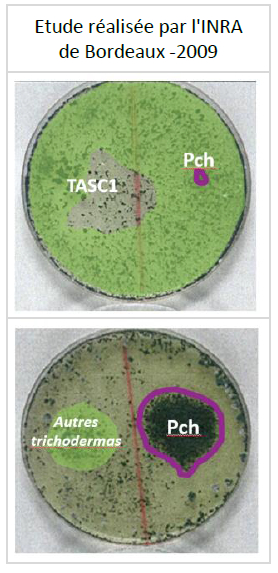

Fin d’hiver, la taille se termine et la vigne attend les beaux jours pour redémarrer (débourrement).
Cependant, au cours du printemps, les principaux pathogènes présents contaminent les plaies liées à la taille exécutée quelques mois auparavant. La vigne ne cicatrise pas rapidement et les plaies restent ouvertes, constituant ainsi des portes d’entrée pour les agresseurs :
- Pch = Phaeomoniella chlamydospora
- Pal = Phaeoacremonium aleophilum
- Bot = Botryosphaeria spp
- …

Les plaies de tailles restent réceptives aux contaminations durant une longue période de 4 mois ou plus (la période varie en fonction du pathogène), mais le moment le plus réceptif aux infections varie entre 2 et 8 semaines après la taille.
En absence de toute protection, les pathogènes vont se développer dans les vaisseaux conducteurs et vont petit à petit coloniser l’intérieur de la vigne. Le flux de sève va diminuer et ainsi la vigne sera moins résistante au stress hydrique. A terme, cela entraîne les phénomènes dits d’ESCA ou de BDA (aujourd’hui appelé dépérissement à Botryosphaeria). S’en suit, une mort rapide (forme apoplectique) ou une forme lente laissant apparaître des symptômes caractéristiques sur feuilles et sarments. Rapidement la production ainsi que la durée de vie de la vigne diminuent.
Complanter coûte cher. Le travail est fastidieux et les vignes deviennent hétérogènes car composées de ceps de tous âges.
En appliquant VINTEC après la taille et avant les contaminations, celles-ci sont fortement réduites et VINTEC "ferme la porte" aux pathogènes. Ainsi la vigne conserve sa vigueur et son potentiel.
Pourquoi VINTEC est-il particulièrement adapté à lutter contre les pathogènes de l’ESCA ?
1- VINTEC a été découvert en Italie et isolé directement dans le bois et non dans le sol. Ainsi lorsque qu’il s’installe dans les plaies de taille, VINTEC retrouve son espace originel et reste compétitif une grande partie de l’année.
2- TASC1 est une souche virulente de Trichoderma atroviride, fortement compétitive au niveau nutritionnel. Elle empêche les pathogènes de se développer.
3- Enfin, VINTEC possède un effet antibiose qui lui permet de limiter le développement des champignons déjà présents.
Photo : TASC1 (en vert) colonise très rapidement l'espace et empêche le pathogène Pch de se développer.
Comment s’applique VINTEC :
VINTEC s’applique directement sur les plaies de taille avant le début du gonflement des bourgeons. Cette souplesse d’utilisation permet de se consacrer pleinement à la taille avant de protéger la vigne contre l’ESCA et le BDA.
Le matériel utilisé peut être un pulvérisateur à dos ou un matériel de pulvérisation classique. L’utilisation de panneaux récupérateurs permet une application optimisée.

Privilégier les applications lorsque la température devient supérieure ou égale à 10°C au cours de la journée, car VINTEC colonise plus rapidement la plaie de taille à partir de cette température.
Pour un résultat optimal, veiller à ce que l'application soit suivie d'une période de 24 heures sans pluie, ni gel.
CONCLUSION :
En empêchant durablement la contamination des plaies de taille par les champignons pathogènes responsables de l’ESCA et BDA, VINTEC contribue fortement à lutter contre le dépérissement de la vigne et constitue un outil majeur et complémentaire pour pérenniser votre capital.
Au fil des années, vos vignes sont protégées et votre capital est préservé
Plus d'info sur : http://www.belchim.fr/index.php/vintec